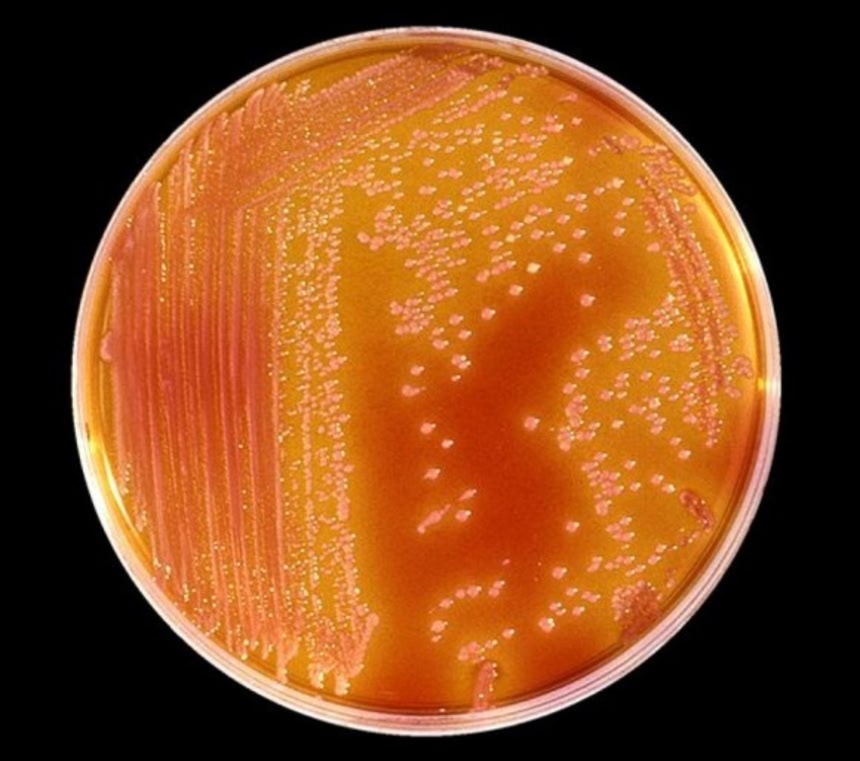

この画像を大きなサイズで見る
この画像を大きなサイズで見る科学者らが、人工的に火星環境を作り、地球上で単離した微生物を置いたところ、一部の微生物は赤い惑星でも生存できる可能性が示された。
太陽系内にある全惑星の中で、火星の環境は地球のそれに最も近い。
科学者は、この惑星にかつて生命が存在したのかどうか、そして現在の厳しい気候条件においてさえも生命、それが微生物であったとしても存在するのかどうかに関心を寄せている。火星の大気の組成は、二酸化炭素がおよそ96パーセント、アルゴンが2パーセント、窒素が2パーセントであり、そこにわずかな酸素と水が存在する。
 この画像を大きなサイズで見る
この画像を大きなサイズで見る研究テーマは2点あった。1つめは、火星上で生命が生存できるのか否か確認することであり、これは微生物なら明らかにできる。2つめは、将来的に宇宙飛行士が火星へ微生物を持ち込んだ場合、これが火星の環境でも生存できるのかどうか知ることだ。
今回の実験は、特定の綱の微生物を取り上げたもので、メタン菌が使われた。この生物は、水素をエネルギー源としているほか、炭素源として二酸化炭素まで利用している。古細菌に分類されるメタン菌は、こうしたエネルギー源を代謝して、メタンを産生する。牛の胃袋に広く見られ、物質の腐敗に関連している。
この微生物に関心が向けられた理由は、生存のために酸素を必要とせず、特殊な環境下でも生存し、成長する能力ゆえに、火星のような厳しい環境下の惑星においても生きれる可能性があったからだ。また、低圧力や低温下にも耐えることができる。
この画像を大きなサイズで見る
この画像を大きなサイズで見る実験に使われたのは、Methanothermobacter wolfeii、Methanosarcina barkeri、Methanobacterium formicicum、Methanococcus maripaludisの4種だ。また、実施場所は米アーカンソー大学である。
なお、2015年1月には、火星探査機キュリオシティが火星で生命の名残を発見した可能性があると発表されている。これは岩石に微生物のような生命体に由来すると思われる微細な痕跡が発見されたことを受けてのものだ。だが、決定打となる生物学的証拠は、今のところ見つかっていない。
















もしかすると火星にも生物がいる可能性があるのかな?
※1
太古に水が存在した形跡があるから、当時は微生物がいた可能性はあるが
何らかの環境変化より、火星の大気が著しく減少し気圧がさがると
地表の水は蒸発してしまう
液体の現存は無理だから、火星に生物が生き残ってるとしたら地面奥深くの氷中の微生物ぐらい
探査機で地表を調べても生物は発見されてないし
アンドロメダ病原体のようにやべー細菌だと
宇宙全域やられそうで怖い
一説には納豆菌も半端でなく強いので宇宙圏外でも
生き残り、宇宙船内で納豆を食べれるとき来るかも
太陽温度が火星環境に影響を与えるほど大きく変化したという科学的知見は聞いたことがないです。現在、地球の地質調査で知られている太陽変動周期で最長のものは、2300年周期のハルシュタット周期で、火星にまで影響を与える規模のものではないです。
芽胞を形成する細菌なら、芽胞状態のまま生き延びることは比較的簡単だろうね。
増殖となると条件が厳しいけれども。
見出し文が少ない記事って速報感があってわくわくする
ほんの2~30年前まではこういう話をしてもオカルト扱いで失笑されるだけだったのに、どんどん現実味を帯びて来る感じがワクワクするねー。
水について一切触れてない時点で
全く納得のいかない記事。水があるのかないのかだけが重要なのに。
酸素がないとか高温高圧とか、そんな些細な事はいくらでもクリアする生物が
地球上にいる。しかし水なしで生きられる生命はゼロ。
コケとバクテリアを火星にばら撒いてみれば、いずれ一面緑の大地になるのではないか。
テラフォーマーズの時代くる?
ヴァイキング計画の時に、予備実験としてやってなかったのかな?
地球上で組み立てられた着陸船に付着した細菌類を誤認識しない為に。
※10
ホントにゼロだろうか?
今、地球にいないだけで・・・ホントにゼロだろうか?
※10
地球育ちだから生活のベストポジションは地球で水も必要だと思うのだろうけど地球外生命体は水なしで生活するのが当たり前かもしれんよ?水が必要な時点で劣等生物かもしれん
ただ、そうゆう知的生命体を発見しても陸の上と海の中のようでコミュニケーションをとるのは難しいかもね
※10
※20
オレも問題は水だと思ったけど。
生存自体には水は決定的なほどには重要じゃないんだ。実際クマムシとか超乾燥状態も絶対零度付近でも生き延びるし。だから、極限環境に生きる古細菌が生存するのもそれほど驚くことじゃない。
でも、生命の発生にはまとまった量の溶媒が必要になる(もし生命が化学反応で発生するものなら)。極限環境で生き延びる生物が居ることが、その環境で生命が発生しうることの根拠にはならないんだよね。残念ながら。
この実験はテラフォーミングの道を開くものだから価値は高いんだけどね。
火星のバクテリアは地球でも生存可能だった事が判明
なんてことがそのうちわかるといいんだけどね
本文中にあるけどメタン生成菌はバクテリア(細菌)じゃなくてアーキア(古細菌)だからタイトルに微妙に語弊があるね
あと、コメントにあるように実際Bacillus属細菌は宇宙船の外壁からとってこられたやつがいるくらいだからすごいよね
実はアポロの時に、それ以前に月に到達した探査機を現地で調査したら、地球で組み立てた時に付着した細菌がまだ生きていたというガチな調査報告があったりする
※14※20
もちろん地球型生命体の話ですだよ。
全ての地球型生命体は「水」が必要だから
地球型生命体である限り水のない空間で生きる事は出来ない。
※14
今の火星には気圧が低すぎて液体の水が存在しない状態
この環境で生物がいるなら、月にだっているかもな
銀河を構成する星の中で、記事は地球と火星の2つに限った話でしょう?
生存可能な星がもっとありそうでワクワクします!!
バクテリアンめ!(KONAMI感)
砂漠のサボテンが高温多湿下では生きていけないように、今の火星の環境に合わせて生きている生命がいても、仮に地球に紛れ込んでも生きてはいけないだろうけど、もし火星に過去湿潤な気候があって、そこで繁殖していた生命が休眠状態で今もいたとして、それが地球に来たらちょっと危ない。かなり強力な競争力を持っていそう。あと、地球から紛れ込んだ生命が火星で生き延びて、それが戻ってくるのもかなり危険。
SF小説では昔からあったな。
火星に着いて火星のバクテリアを発見したと思ったら昔送った火星探査機のものだったとか。
火星を有人探査して帰ってきた場合、未知の病原菌が地球に来る可能性もあるわけね
これ何培地?
生物火星起源説なんてのもある
※24
>生存自体には水は決定的なほどには重要じゃないんだ。
>実際クマムシとか超乾燥状態も絶対零度付近でも生き延びるし。
それは仮死状態(冬眠)してるからであって、
人間だって1,2時間くらいなら水を飲まなくてもなんともないのと同じで、
クマムシは生命活動を極限まで停止させれるから「その時間」が長いだけに過ぎず、
生命活動を通常に展開させるには水が必要。
なら火星に微生物がいる可能性が大きくなるよね?火星移住危なくない?
サイボーグ化が先か、宇宙進出が先か・・・楽しみだ。
※27
>>実施場所は米アーカンソー大学である。
ってあるから実験室内の過酷環境下での仮想培地
実際に火星に菌類を持ち込むことは禁止されてるからね
※37
どれだろう?ttp://www.astroarts.co.jp/news/2015/04/16brine/index-j.shtml
霧が出来るというにはあった…
火星移住は何らかのトリガーになる可能性が非常に高い。在来の生命の爆殖か、地球の生命のミュータントの爆殖か、その両方か。
人類は火星から移住してきたんだよ!
もうさ、コレでいいよ。ピラミッドだの、体内時計は火星時間とか、水の流れた痕跡発見とか、地表からウランとか、色々と物的証拠そろい過ぎだろ
実は木星や土星のほうが生物がいるのさ
エンケラドスやエウロパより環境が整っている、地熱液体が確実に存在してるし
気圧が膨大なため、着陸できる探査機が作れないだけであってさw
タンパク質でできていない生物ならいるかも?
過去の火星探査機に付着していた細菌・バクテリア・微生物のどれかが生き延びている可能性も考えておかないと。昔はさほど生物汚染を気にしていなかったから、そのまま打ち上げていた。
※35
この間、火星の表面で季節によっては水が流れてるってNASAが発表したんだぜ
宇宙が一点から生まれたとすると、宇宙は一様にだいたい同じ元素からできていると予想されることから、宇宙のことと生命発生のプロセスを知れば知るほど想像を絶するような未知の生命が存在する可能性がどんどん少なくなってしまう。
エウロパやエンケラドスはあくまで地熱で溶けた水中に地球型生命がいる可能性が指摘されているだけなので、タイタンのメタンの海に生物がいるかどうかが、生命多様性の可能性を開く鍵になるだろう
寒天培地に手をつけた実験で思ったけど、火星探査車に寒天培地を搭載して火星の土をぺたってやればわかるんじゃないか。
もし微生物がいるとして、多細胞生物に進化はしないのだろうか?
火星にプールを作っておけば火星の微生物が進化する可能性あるな
早く世界中のゴキブリを集めるんだ
水が不必要な生命体も他の星にはいるかもしれないですよ。
必要と言っている人は実際に調べられたんですか?